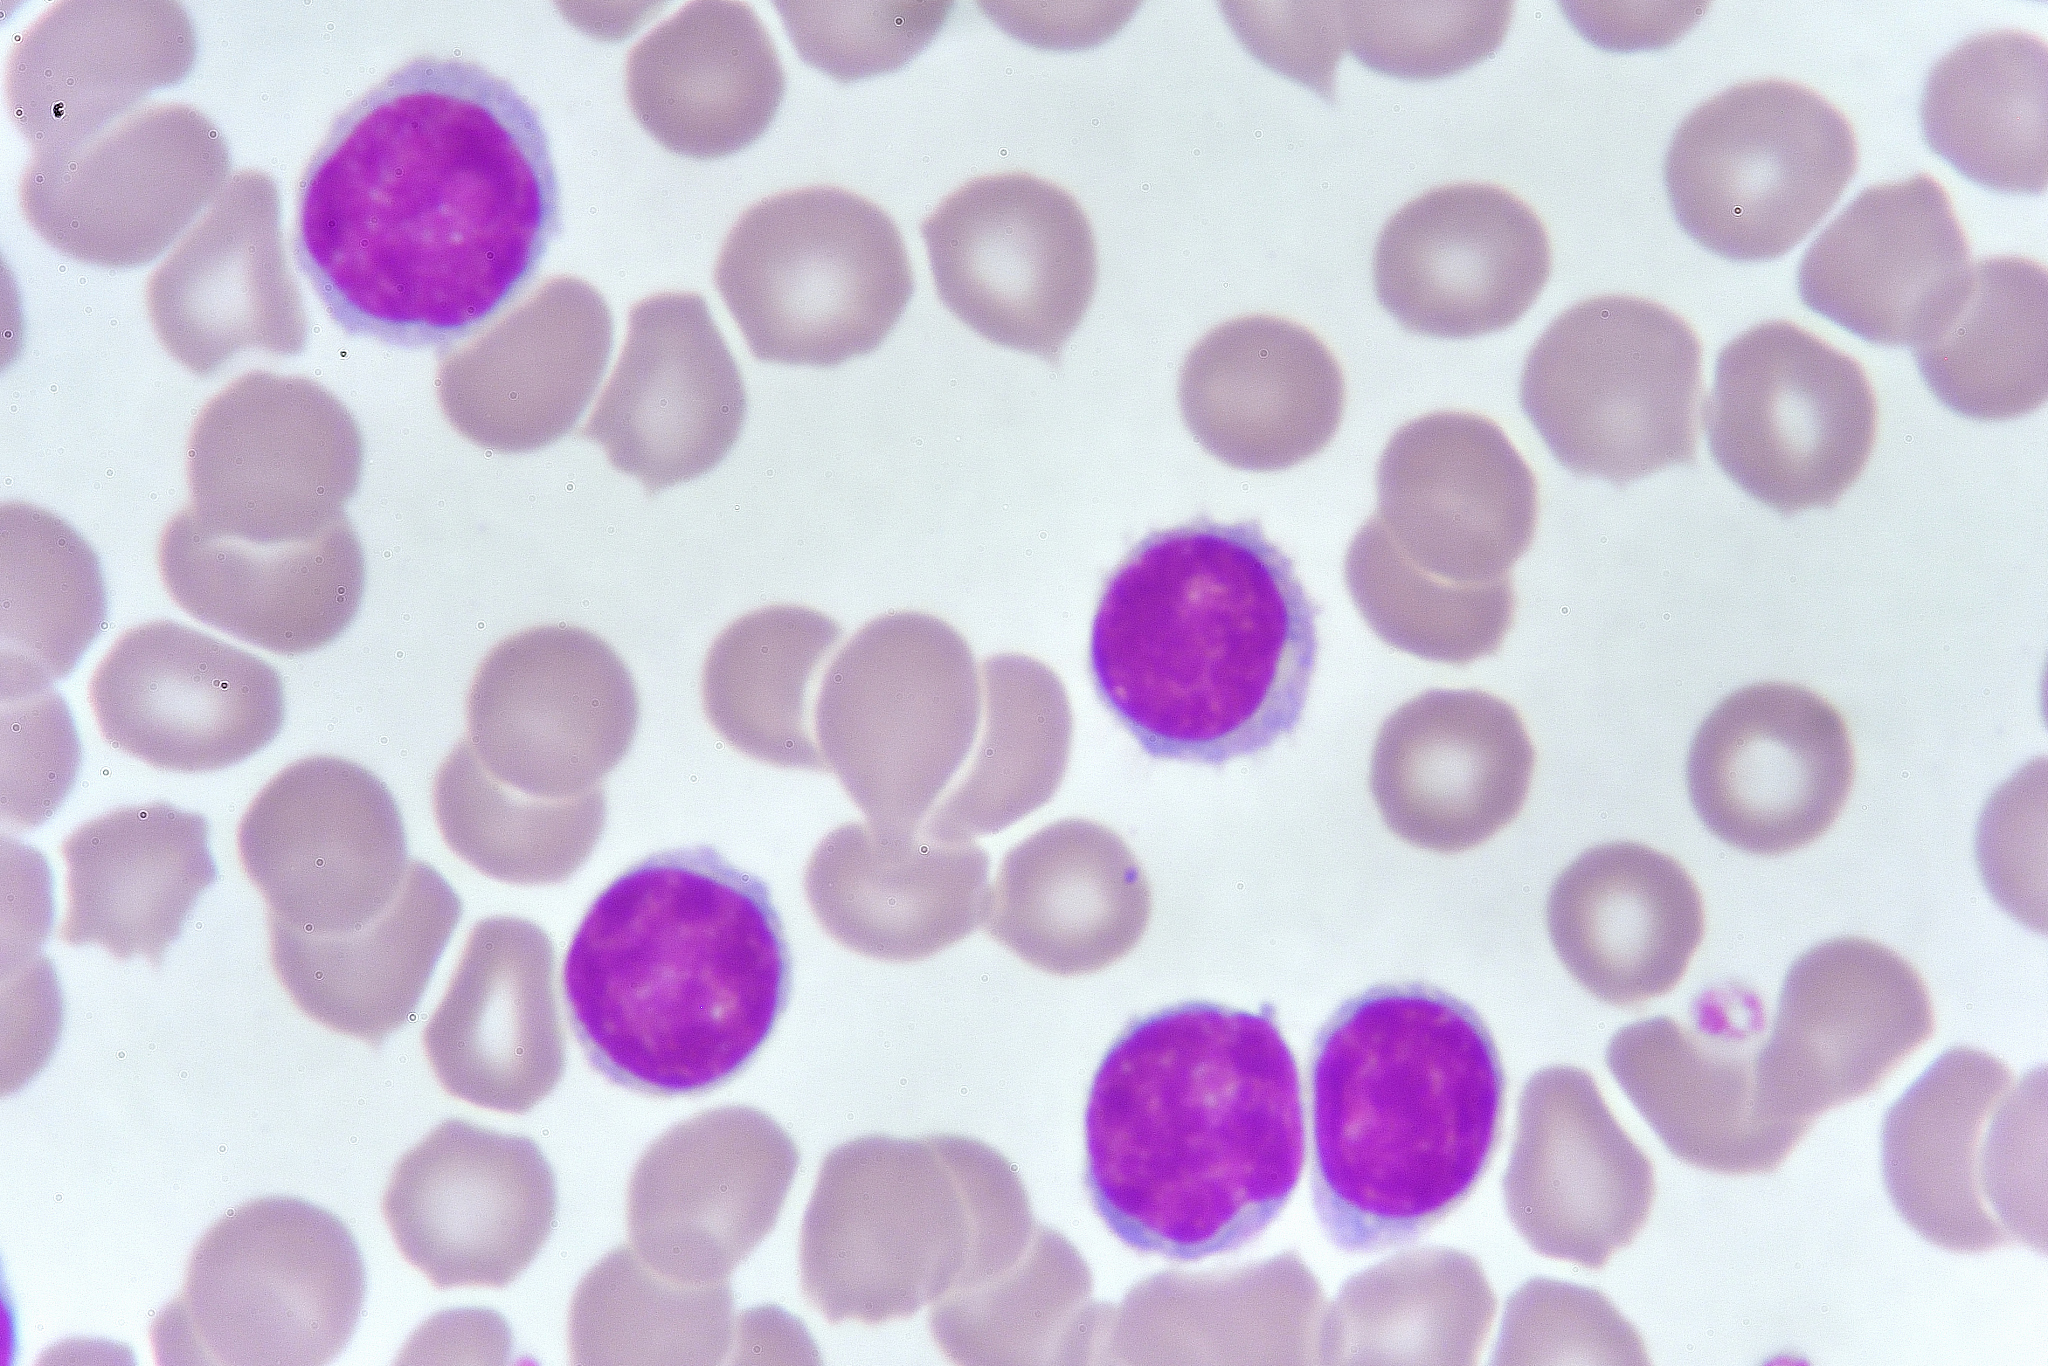
高中信息技术教师工作总结：教学成绩与成果

高中信息技术教师工作总结:教学成绩与成果
作为一名高中信息技术教师,我很荣幸能够在过去的一年里一直在这个领域里学习和教学。我很高兴地看到,我的努力和学生们的努力已经取得了很好的成绩和成果。以下是我对过去一年的工作总结,包括我在信息技术教学方面所取得的成绩和成果。
一、教学目标的实现
在过去的一年中,我在课堂教学方面采用了多种策略和方法,使学生们更好地实现了教学目标。我的教学目标是让学生们掌握信息技术的基本知识和技能,培养他们的分析和解决问题的能力,以及激发他们的创造力和创新意识。
在教学过程中,我采用了多种教学方法,如讲解、演示、实践、小组讨论、课外作业和项目研究等。通过这些方法,我能够更好地激发学生的学习兴趣和积极性,使他们更好地理解和掌握信息技术的知识和技能。
二、学生学习成绩的提高
在过去一年中,我很高兴看到我的学生在信息技术方面取得了很好的成绩和成果。我的学生们在期中和期末考试中的平均分数都有很大的提高,部分学生的成绩甚至在最高分数范围内。此外,我的学生们也在课外活动中取得了很好的成绩,如参加信息技术比赛和项目研究等。
这些成绩和成果的取得,离不开我的教学方法和策略以及学生们的努力和积极性。在未来的工作中,我将继续努力,为学生们提供更好的教学和学习环境,使他们能够更好地学习和成长。
三、教学改进的探索
作为一名信息技术教师,我始终关注教学改进和创新。在过去一年中,我不断探索和尝试新的教学方法和策略,以更好地满足学生的学习需求和提高教学效果。
其中,我尝试了通过在线教学平台和教学视频等方式,为学生提供更加灵活和自主的学习方式。我还通过多媒体教学和课堂互动等方式,使学生们更好地理解和掌握信息技术的知识和技能。
在未来的工作中,我将继续探索和尝试新的教学方法和策略,以更好地促进学生的学习和成长。
四、教学经验和技能的提升
在过去一年中,我不断学习和提升自己的教学经验和技能。我通过参加教学培训和学术研讨会等方式,了解和掌握最新的信息技术教学理论和方法,并将其应用到自己的教学实践中。
此外,我也积极参与学校的教研活动和课题研究,与其他教师共同探讨和研究信息技术教学的最佳方法和策略。
通过这些努力,我取得了很好的成绩和经验,在信息技术教学方面不断提升自己的能力和水平。
五、总结和展望
过去的一年中,我在信息技术教学方面取得了很好的成绩和成果。我的学生们在学习成绩和学习能力方面都有了很大的提高,我也不断探索和尝试新的教学方法和策略,提升自己的教学能力和水平。
在未来的工作中,我将继续努力,为学生们提供更好的教学和学习环境,不断探索和尝试新的教学方法和策略,提升自己的教学经验和技能,为信息技术教学事业做出更大的贡献。
原文地址: https://www.cveoy.top/t/topic/oYFf 著作权归作者所有。请勿转载和采集!